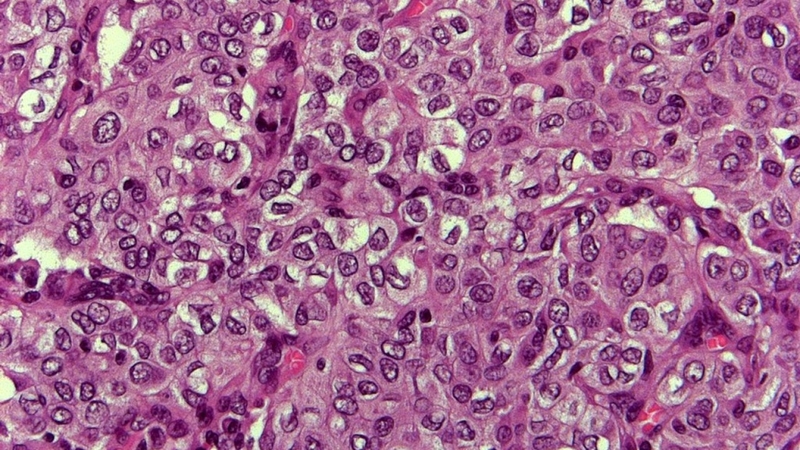
Carcinoma tuyến giáp thể nhú: Hiểu rõ về bệnh lý và cách điều trị hiệu quả 2

Dược sĩ chuyên ngành Dược lâm sàng, với nhiều năm kinh nghiệm làm việc trong lĩnh vực dược phẩm. Là Dược sĩ Long Châu đạt được chứng chỉ bệnh học cấp quốc tế. Hiện đang là giảng viên tại Trung tâm Đào tạo FPT Long Châu.
Ánh Vũ
31/07/2024
Mặc định
Lớn hơn
Khám phá thông tin chi tiết về Carcinoma tuyến giáp thể nhú, một loại ung thư tuyến giáp hiếm gặp nhưng cực kỳ nguy hiểm. bài viết dưới đây của Nhà thuốc Long Châu sẽ giúp bạn tìm hiểu nguyên nhân, triệu chứng, phương pháp chẩn đoán và các lựa chọn điều trị bệnh hiện đại nhất.
Carcinoma tuyến giáp thể nhú là một trong những dạng ung thư tuyến giáp kém phổ biến nhưng lại rất khó điều trị và có thể gây ra nhiều biến chứng nghiêm trọng. Bài viết này sẽ cung cấp một cái nhìn sâu sắc về bệnh lý này, từ nguyên nhân, triệu chứng đến các phương pháp chẩn đoán và điều trị, giúp bạn hiểu rõ hơn về căn bệnh này để có thể phòng tránh và can thiệp kịp thời.
Carcinoma tuyến giáp thể nhú là một dạng ung thư tuyến giáp hiếm gặp nhưng tiến triển nhanh chóng và có thể gây ra các biến chứng nghiêm trọng. Bệnh này phát triển từ các tế bào tạo nhú trong tuyến giáp, nơi sản xuất hormone điều chỉnh nhiều chức năng quan trọng của cơ thể, bao gồm trao đổi chất và năng lượng và thường xảy ra ở những người lớn tuổi hơn. Dù tỷ lệ mắc phải không cao, nhưng tính chất của nó lại đặc biệt nguy hiểm vì khả năng lan rộng nhanh đến các bộ phận khác của cơ thể, bao gồm hạch bạch huyết và các cơ quan lân cận. Việc hiểu rõ về căn bệnh tuyến giáp này và các lựa chọn điều trị sẽ giúp người bệnh và gia đình họ đối mặt và vượt qua thử thách này một cách hiệu quả hơn.

Một số nguyên nhân phổ biến có thể gây ra carcinoma tuyến giáp thể nhú bao gồm:
Carcinoma tuyến giáp thể nhú là một dạng ung thư tuyến giáp có thể phát triển mà không gây ra triệu chứng rõ ràng cho đến giai đoạn nặng. Tuy nhiên, sự nhận biết kịp thời các dấu hiệu và triệu chứng sớm có thể đóng vai trò quan trọng trong việc chẩn đoán và điều trị bệnh. Dưới đây là một số triệu chứng và dấu hiệu cảnh báo của carcinoma tuyến giáp thể nhú mà mọi người cần lưu ý:
Việc theo dõi sức khỏe và thực hiện các xét nghiệm định kỳ là rất quan trọng, đặc biệt nếu bạn có các triệu chứng nêu trên hoặc có tiền sử gia đình mắc bệnh ung thư tuyến giáp. Phát hiện sớm và can thiệp kịp thời có thể cải thiện đáng kể khả năng điều trị và tỷ lệ sống sót của người bệnh.

Phương pháp chẩn đoán Carcinoma tuyến giáp thể nhú đòi hỏi sự chính xác cao và thường bao gồm một loạt các xét nghiệm để xác định chính xác tính chất và mức độ của bệnh. Hiểu rõ về các phương pháp chẩn đoán này không chỉ giúp phát hiện sớm bệnh mà còn hỗ trợ bác sĩ trong việc lựa chọn phương pháp điều trị phù hợp. Dưới đây là những phương pháp chẩn đoán chính được sử dụng để phát hiện carcinoma tuyến giáp thể nhú:
Các phương pháp này, khi được sử dụng kết hợp, mang lại cái nhìn toàn diện về tình trạng bệnh, từ đó giúp đưa ra kế hoạch điều trị hiệu quả và cá nhân hóa cho từng bệnh nhân. Việc chẩn đoán sớm và chính xác là yếu tố then chốt trong việc tăng cơ hội điều trị thành công cho bệnh nhân mắc carcinoma tuyến giáp thể nhú.

Carcinoma tuyến giáp thể nhú là một trong những dạng ung thư tuyến giáp có tiên lượng tốt khi được phát hiện và điều trị kịp thời. Việc lựa chọn phương pháp điều trị phụ thuộc vào giai đoạn của bệnh, sức khỏe tổng quát của bệnh nhân và các yếu tố cá nhân khác. Dưới đây là những lựa chọn điều trị chính cùng với tiên lượng cho bệnh nhân mắc Carcinoma tuyến giáp thể nhú:
Nhờ các phương pháp chẩn đoán và điều trị tiên tiến, đa số bệnh nhân mắc carcinoma tuyến giáp thể nhú có tiên lượng tốt, với tỷ lệ sống sót 5 năm sau khi chẩn đoán cao. Tuy nhiên, tiên lượng cụ thể có thể khác nhau tùy theo từng trường hợp cụ thể, bao gồm giai đoạn của bệnh và phản ứng với điều trị. Việc phát hiện sớm và theo dõi định kỳ là chìa khóa để cải thiện tiên lượng và chất lượng cuộc sống cho bệnh nhân.
Trong bài viết trên, Nhà thuốc Long Châu đã cung cấp cho bạn một cái nhìn tổng quan về Carcinoma tuyến giáp thể nhú, một dạng ung thư tuyến giáp ít gặp nhưng có thể điều trị được nếu được phát hiện sớm. Việc hiểu rõ về các triệu chứng, phương pháp chẩn đoán và điều trị sẽ giúp bệnh nhân và người nhà có những bước tiếp cận tốt nhất trong việc quản lý bệnh. Luôn tham khảo ý kiến bác sĩ chuyên môn để nhận được sự chăm sóc phù hợp và kịp thời. Hy vọng rằng thông tin từ bài viết này đã mang lại cho bạn những kiến thức bổ ích và hữu ích trong việc phòng ngừa hoặc đối mặt với căn bệnh này.
Xem thêm:
Dược sĩ Đại họcPhạm Nguyễn Hoàng Kim
Dược sĩ chuyên ngành Dược lâm sàng, với nhiều năm kinh nghiệm làm việc trong lĩnh vực dược phẩm. Là Dược sĩ Long Châu đạt được chứng chỉ bệnh học cấp quốc tế. Hiện đang là giảng viên tại Trung tâm Đào tạo FPT Long Châu.